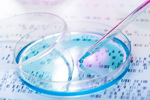
Genetic Research-GettyImages-477335408

ARTICLES BY ANTONY HITCHCOCK
-
Do We Really Understand Plasmid Quality's Effects On mRNA Production?5/1/2025
Two experts examine the current guidelines and specs for plasmid DNA and question whether our understanding is sufficient.
-
Sourcing Plasmid DNA From CDMOs Got More Challenging — Here's Why11/19/2024
The demand for plasmid DNA products is intrinsically linked to unique market conditions and funding environments. Here's what's driving them.
-
Have We Got Novel Drug Production And Compliance Timelines All Wrong?6/13/2024
Drug developers might want to consider longer-term approaches to meeting manufacturing and regulatory requirements.
-
What Proposed Plasmid DNA Standards Say For GMP/Non-GMP Production3/8/2024
Today’s standards for plasmid DNA production lack specificity, and manufacturers have been clamoring for more. In late 2023, USP published draft General Chapter <1040> to help fill in the cracks.